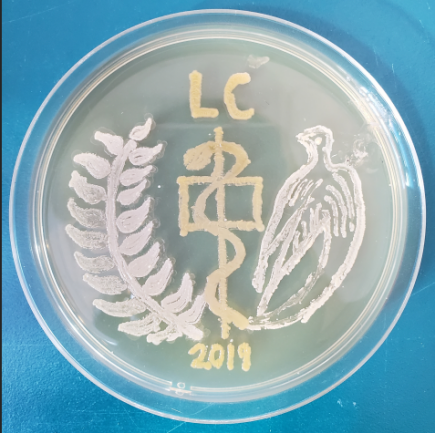
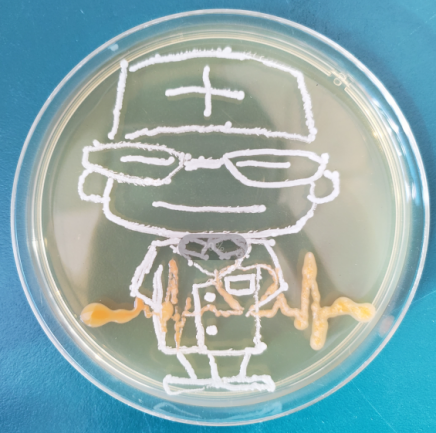
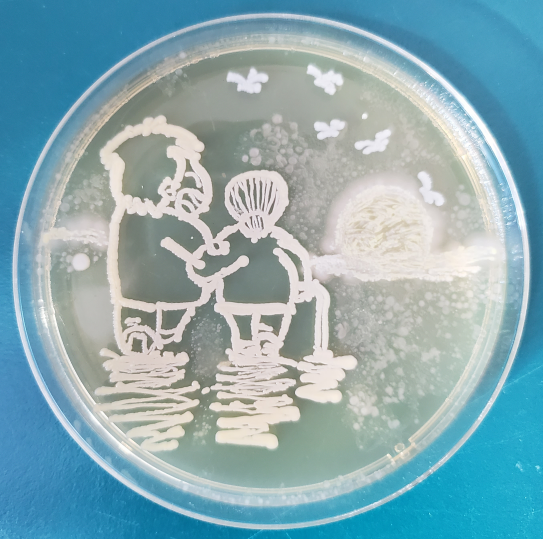
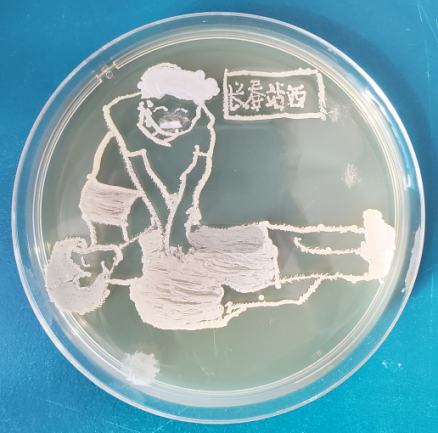
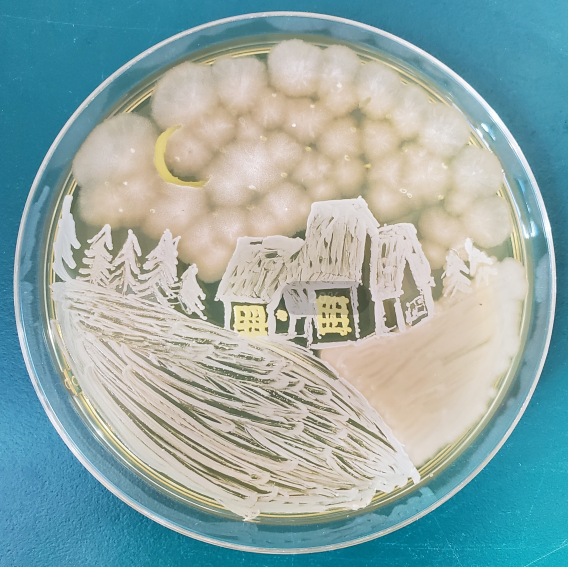

开云kaiyun官方网站首届微生物培养皿艺术大赛圆满结束
为了贯彻落实国务院办公厅印发《关于深化高等学校创新创业教育改革的实施意见》精神,为了更好地帮助学生发现生命科学的乐趣,激发对生命科学的热爱,提升科学素养培养学生创新思维及创造力,提升团队协作和动手实验能力,挖掘学生利用科学知识及创新意识去发现问题、解决问题的潜能。由开云kaiyun官方网站教务处、创新创业学院主办,开云kaiyun官方网站承办的
“开云kaiyun官方网站首届微生物培养皿艺术大赛”决赛于2019年3月27日在四象城3411举行。
本届“开云kaiyun官方网站首届微生物培养皿艺术大赛”以“初心”为主题,以培养基平板细菌为依托,将科学、人文与艺术相结合,比拼微生物学基本知识、实验操作的规范性、主题创意设计和艺术创作,全面考察学生的综合素质。

本次大赛于
2019年3月开启,由开云kaiyun官方网站微生物与免疫教研室主任周宏负责组织实施,共收到由各学院本科生组成的28组团队近百幅创意作品。经过初赛评选共有30幅优秀作品入围决赛,最终评选出一等奖1名、二等奖3名、三等奖5名及优秀奖若干。

本次“开云kaiyun官方网站首届微生物培养皿艺术大赛”丰富了大学生课余生活不仅提升了在校大学生的动手实验能力,还提升了学生的创新思维。学生将在校所学与生活、艺术、文化等各个层面相结合,真正做到寓教于乐,学以致用。大学生创新思维和创新实践能力的培养是高校人才培养的重中之重,创新型人才的培养是高校责任所在。衷心感谢本次大赛的各位参赛选手以及指导、支持、关注本次大赛所有领导和老师,也期待未来的赛事能有更广泛的参与,涌现更多优秀的作品。
撰稿人:史文婷
审稿人:汤勇